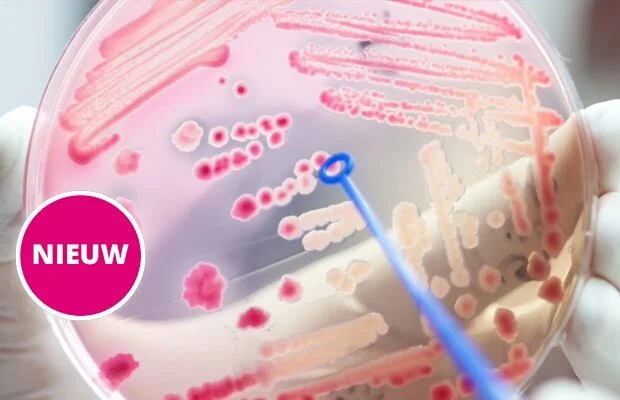
BRMO in de thuiszorg

Klik op een thema om het aanbod te zien
Allyoucanlearn heeft een grote variatie aan leeronderwerpen. Om het makkelijker te maken hebben we deze opgedeeld in verschillende thema’s. Klik op een thema om te zien welke modules deze bevat. Ben je een zij-instromer wil je de overstap maken naar Zorg en Welzijn? Klik dan op deze link om het uitgebreide aanbod te bekijken!
Communicatie
Padlet toepassen in je (afstands)les: 1. bord aanmaken, bord beschikbaar stellen.
Hoe leer je jongeren respectvol met elkaar omgaan als het gaat om seks? Wat is experimenteren en wanneer is het schadelijk voor voor henzelf of iemand anders? En hoe voorkom je seksueel grensoverschrijdend gedrag? Maak kennis met de succesvolle methode ‘Ik ben van mij!’ die uitgaat van jongeren zelf. Tijdens deze online cursus krijg je onmisbare achtergrondinformatie, vergroot je je inzicht met reflectievragen en oefen je met voorbeelden uit de praktijk.
Alle lesbische vrouwen, homoseksuele mannen, biseksuelen, transgender (LHBT’s) hebben een fase waarin ze vragen hebben over hun seksuele identiteit. Zij krijgen regelmatig te maken met negatieve reacties, uitsluiting, pesten en soms zelfs geweld. Zij zullen hun LHBT gevoelens daarom niet zomaar inbrengen in een gesprek. Hoe ga je hier als professional mee om? In deze geaccrediteerde module krijg je informatie over LHBT en ga je aan de slag met casussen. Je leert hoe je LHBT gevoelens bespreekbaar maakt.
Deze module is geschikt voor iedereen die beter wil leren presenteren voor kleine en grote groepen.
Met het doorlopen van deze module leer je hoe je op een cultuursensitieve en persoonsgerichte manier gesprekken aangaat met mensen met een vluchtelingenachtergrond.